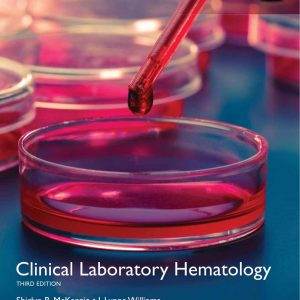
Clinical Laboratory Hematology 3rd edition global

Get the knowledgeable steerage that you must present your sufferers with the absolute best outcomes with Hematology: Basic Principles and Practice, 7th Edition, (PDF). This totally up-to-date textbook accommodates each unparalleled scientific content material and should-know medical steerage, so you may enhance your downside-fixing expertise and make the very best use of the most recent diagnostic strategies and therapeutic choices on this quick-altering area.
- Provides state-of-the-artwork info and steerage from editors and world contributors who’re on the entrance of their respective subspecialty areas.
- Includes a number of new chapters together with Epigenetics and Epigenomics, Stem Cell Model of Hematologic Diseases, IND Enabling Processes for Cell-Based Therapies, Multiple Myeloma, and Immune Checkpoint Blockade in Hematologic Malignancies.
- Features sweeping content material updates all through, together with primary science analysis which serves as a basis for contemporary hematology, latest advances in stem cell transplantation, medical advances within the therapy of every of the hematologic malignancies, molecular diagnostics, immune checkpoint inhibitors, transfusion drugs, and rather more.
NOTE: The product contains the ebook, Hematology: Basic Principles and Practice, 7e in PDF. No access codes are included.

Reviews
There are no reviews yet.